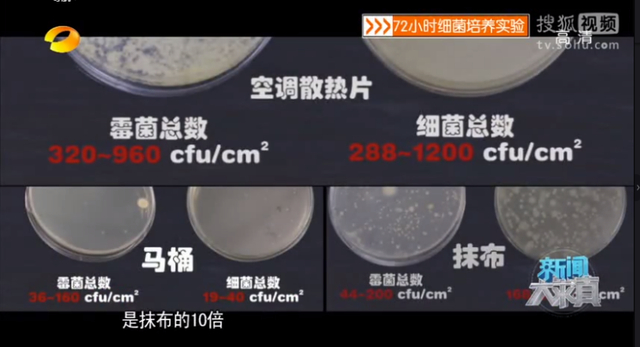

恰值换季,问一个深入灵魂的问题,你家空调洗了吗?
湖南卫视《新闻大求真》节目就对一台没有清洗过的空调进行过测试,结果发现:空调散热片的细菌含量是——马桶的60倍,是抹布的10倍!

也就是说,没有清洗过的空调,比生活中的抹布、马桶细菌还要多。
更重要的是,在空调散热片中还检出了金黄色葡萄球菌、军团菌等十几种致病菌。

长时间呼吸在污浊的空调房内呼吸,可不仅“空调病”那么简单,严重的话真能吹进ICU!

由此可见,定期清理空调是重要但是又常常被忽视的。
今天就给大家推荐一个空调清洗剂,杀菌除螨、清洁抑味一瓶搞定,TA就是:Nature Wellbeing空调除螨清洁剂

强烈推荐理由
① 有效除螨、抑菌、除垢、祛味,除菌率高达99.9%;
② 澳洲特有的天然桉树植物精油,安心可靠;
③ 浓缩型泡沫,一喷即清洁,方便便捷;
④ 家用空调、车载空调、电风扇全面适用;
⑤ 500ml大容量,一瓶清洁3台空调;
活动优惠价
49元买一送一
1
除螨杀菌 除垢祛味
双效合一 不伤空调
单纯地清洗并不能达到除螨抑菌的效果,这时候空调除螨清洁剂就显得特别重要了。

先上官方检测报告!看看这优秀的灭螨率!

它对于大肠杆菌、金黄色葡萄球菌的杀菌率也相当高,高达99.9%。

优秀的效果来源于优质的原材料。安全放心味好闻这款空调清洁剂的主要成分是来自澳洲本土桉树的植物精油。

桉树精油有一种特殊的气味,闻起来有点类似薄荷的味道,但这却是可以杀死螨虫的味道,它可以直接切断螨虫的脑神经接受信息,使螨虫进入深度睡眠直至死亡。
久不清洗的空调,吹出来的风总是会有一股味儿。桉树精油不仅能够祛味,还能够进化空气,让吹出来的风更健康自然。

天然植物萃取成分,不会损害、腐蚀空调内部,安全可靠。

只要不对桉树精油过敏,儿童房的空调照样放心用。

活动优惠价
49元买一送一
2
一喷完成清洁
使用方便 多场景适用
这款空调除螨清洁剂使用方法十分简单,只需简单4步。
第一步:摇晃几下后,拿下瓶身上附带的喷管,插进喷口孔。

第二步:拔掉空调电源(切记!)打开空调盖将过滤网取下来。

第三步:将清洁剂喷洒到散热片上,注意一定要避开电路板,然后静待15分钟。同样将过滤网上喷洒清洁剂,静待5分钟。

第四步:散热片的清洁剂也差不多溶解后用抹布轻轻擦干净印迹,同时用清水冲洗干净过滤网,晾干后装回空调,再装好空调盖。

30分钟后再开空调使用,污水会自动从排水管排出。整个清洁过程就完成啦。除了过滤网其余的部分都不需要拆卸,用后也无须再用清水过洗,非常方便。

这款空调清洁剂喷出来的是浓缩型泡沫,附着力很强,能长时间停留物体表面迅速高效瓦解污渍。
再配合它的加长导管,强劲喷力可迅速深入散热片内部,更加彻底地杀菌除螨。

除了室内的立式、挂式空调需要清洗之外,汽车上的空调也不容忽视。

车内空间狭小,更容易积聚各种细菌,对健康造成威胁。车载空调定期做清理就显得更重要了。

这款清洁剂使用于多种空调以及电风扇。

另外,中央空调、大型空调、空调外机,甚至灯具等等都可以用它做清洁,使用场景非常广泛。

活动优惠价
49元买一送一
3
1瓶可洗3台空调
净化全家空气 改善制冷效果
这款空调清洁剂有500ml超大容量,内含浓缩型泡沫,一瓶清洗3台2P或2P以下的空调是基本没问题的。

除了每年换季首次开机和封闭存放前进行换季清洗,日常清洗也是很必要的。
如果在使用过程中闻到异味,或者感觉制冷效果不佳了,这就意味着你该清洗空调了。

其实夏天空调用的勤,连续使用2-3个月就应该给空调做一次清洁。定期清洁不仅仅让我们呼吸的空气更加干净,亦可提升机器性能,延长机器使用期。

像散热板清洗后,空调动作会更高效,制冷制热更迅速,节约电能。
原价59元/瓶,活动优惠价:49元买一送一,到手2瓶!完全足够在夏天来之前给全家空调完成清洁,守护全家健康!

温馨提示:
1、如何查看订单?
微信搜索“哇塞好物精选”,选择小程序,点击右下角【我的订单】即可查询;
2、发货时间
付款成功后,48小时内发货(节假日除外),烦请耐心等候~
3、售后/退货
如遇问题,可在“我的订单”中选择您要咨询的订单,选择【在线客服】进行咨询;
4、客服在线时间
周一至周五(工作日)-09:00-18:00;节假日在线时间不固定。


